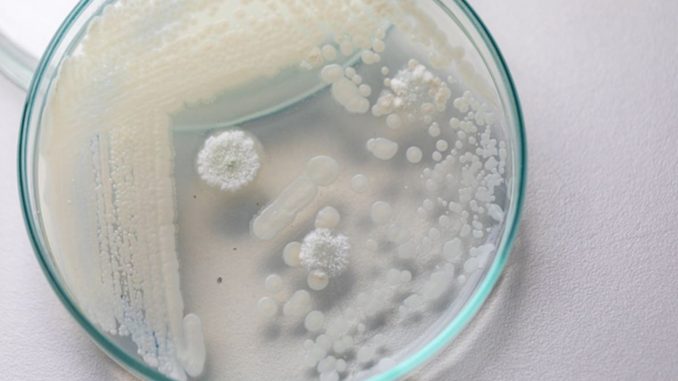

O Centro Europeu de Prevenção e Controle das Doenças (ECDC) emitiu nesta quinta, 11, um alerta sobre a disseminação acelerada do fungo Candidozyma auris (C. auris) em hospitais do continente. Altamente resistente a medicamentos, o micro-organismo representa risco grave para pacientes críticos e ameaça os sistemas de saúde pela dificuldade de controle em ambientes hospitalares.
Entre 2013 e 2023, foram registrados mais de 4 mil casos em países da União Europeia e do Espaço Econômico Europeu, com destaque para o salto ocorrido em 2023, quando foram confirmados 1.346 episódios em 18 países. Espanha, Grécia, Itália, Romênia e Alemanha concentram a maioria dos registros, enquanto surtos recentes foram detectados também em Chipre e França.
Segundo o ECDC, a ausência de sistemas nacionais de vigilância em grande parte dos países contribui para a subnotificação e dificulta respostas rápidas. Apenas 17 das 36 nações monitoradas possuem programas oficiais para acompanhar o avanço do C. auris, e só 15 contam com protocolos específicos de prevenção.
O fungo tem capacidade de sobreviver em superfícies e equipamentos médicos por longos períodos, favorecendo a transmissão entre pacientes hospitalizados. Casos isolados se transformaram em surtos de larga escala em poucos anos, demonstrando a velocidade de propagação. Autoridades destacam que, embora a situação seja preocupante, medidas precoces e coordenadas ainda podem conter o avanço.
Portugal notificou apenas quatro casos em 2023, enquanto a Espanha ultrapassou 1.800 e a Grécia contabilizou mais de 850. Para especialistas, o momento é decisivo para que governos reforcem protocolos de higiene, rastreamento e isolamento em unidades de saúde.
COM INFORMAÇÕES DE AGÊNCIAS





Be the first to comment